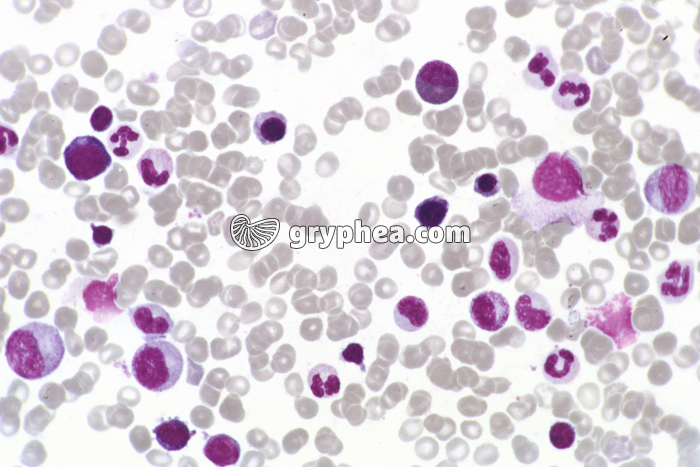
Moelle osseuse x170 - gryphea.com

Type : Photographie
Référence : C 3314
Auteur : Hervé Conge
Edition et PresseNumérique et Internet
Valeur du crédit
1 crédit = 6.00€ TTC
(Hors pack)
1 crédit = 6.00€ TTC
(Hors pack)
si vous êtes enseignant, le site gryphea.org a été conçu spécialement pour vous !
Edition et Presse
Paramètres additionnels
Tirage
Distribution
Durée d'utilisation
Droits numériques en sus
Total : crédits
Ajouter au panier
Numérique et Internet
Paramètres additionnels
Numérique
Internet
Durée d'utilisation
Total : crédits
Ajouter au panier
Numérique et Internet
Paramètres additionnels
Numérique
Internet
Durée d'utilisation
Total : 4 crédits
Ajouter au panier
Légende :
La suite du commentaire est réservée aux inscrits, créez un compte gratuitement.
Organe situé à l’intérieur des os, sous la forme de tissu adipeux (moelle jaune localisée dans la diaphyse des os longs) ou de tissu très riche en cellules sanguines (moelle rouge de l’os spongieux, localisé dans les épiphyses des os longs ou dans les os plats). La moelle rouge est responsable de la synthèse des cellules du sang, comme les globules rouges, et celles du système immunitaire, comme les globules blancs et les plaquettes sanguines.
La suite du commentaire est réservée aux inscrits, créez un compte gratuitement.
Thèmes associés :
Sang et système circulatoireSystème immunitaire